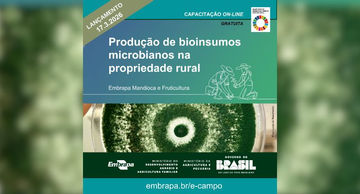
Embrapa lança capacitação sobre produção de bioinsumos

top of page
Buscar


SESCOOP/SC divulga Relatório de Gestão 2025
Documento reforça transparência, governança e impacto das iniciativas no desenvolvimento das cooperativas catarinenses O Serviço Nacional de Aprendizagem do Cooperativismo no Estado de Santa Catarina (SESCOOP/SC) divulgou o Relatório de Gestão 2025, reunindo as principais ações, investimentos e resultados do período. O documento reforça o compromisso da instituição com a transparência, a governança e o fortalecimento do cooperativismo no estado. Ao longo do ano, o SESCOOP/SC
27 de mar.1 min de leitura


Santa Catarina discute parcerias para impulsionar a ovinocultura
Santa Catarina avança no fortalecimento da ovinocaprinocultura ao investir em parcerias estratégicas voltadas à inovação e ao aumento da produtividade no campo. Nesta semana, representantes do Projeto de Fortalecimento da Ovinocaprinocultura no Estado estiveram na Embrapa Pecuária Sul, em Bagé (RS), para prospectar cooperações que impulsionem o desenvolvimento integrado de toda a cadeia produtiva — da produção ao processamento e à comercialização da carne ovina. A Secretaria
27 de mar.2 min de leitura


Carnes: Guerra pressiona produção e desafia cadeia exportadora de Santa Catarina
O acirramento de tensões no Oriente Médio, envolvendo Estados Unidos, Israel e Irã, já provoca reflexos diretos na cadeia global de produção e exportação de carnes. Para Santa Catarina, líder nacional na produção de suínos e segundo maior produtor de aves, os efeitos vão desde o aumento de custos logísticos até riscos na previsibilidade de mercados estratégicos. Segundo o diretor executivo do Sindicarne (Sindicato das Indústrias da Carne e Derivados no Estado de SC) e da ACAV
27 de mar.3 min de leitura

Embrapa lança capacitação sobre produção de bioinsumos
A Embrapa lançou, nesta semana que passou no seu novo curso on-line e gratuito “Produção de bioinsumos microbianos na propriedade rural”. A apresentação foi durante a Feira Nacional de Máquinas e Tecnologias para a Agricultura Familiar, em Campinas (SP). A capacitação é voltada para agricultores familiares, cooperativas rurais e agentes de assistência técnica e extensão rural, e visa a compreensão e aplicação dos fundamentos técnicos, práticos e legais necessários para produz
27 de mar.2 min de leitura


Cooperativas de crédito lideram em número de agências em três estados
Mesmo diante da forte redução da presença física de instituições financeiras no Brasil, o cooperativismo de crédito tem mantido uma trajetória de expansão e proximidade com as comunidades ao redor do país. No cenário atual, marcado pelo fechamento de agências bancárias tradicionais, três estados brasileiros apresentam uma configuração distinta: Santa Catarina, Paraná e Mato Grosso, onde cooperativas financeiras lideram o número de agências no território estadual. O dado evide
27 de mar.2 min de leitura


Sicoob e Visa lançam promoção “Me Leva Junto”, que levará cooperados para assistir à Copa do Mundo da FIFA 2026
Assistir a um jogo na Copa do Mundo da Fifa 2026 pode se tornar realidade para cooperados do Sicoob. Em oferecimento da Visa, a instituição promove a campanha “Me Leva Junto”, que premiará dois cooperados: um do segmento Pessoa Física (PF) e outro de Pessoa Jurídica (PJ), com uma viagem internacional, com direito a acompanhante, para assistir a um jogo do Brasil na Copa do Mundo da Fifa 2026 (oferecimento Visa). A iniciativa integra a estratégia do Sicoob de ampliar o relaci
27 de mar.2 min de leitura


Giro da Safra aponta produtividade do milho no Meio-Oeste acima de 204 sacas por hectare
Projeto realizado pelo Sicoob SC/RS em parceria com a Epagri/Cepa apresentou um levantamento preliminar da safra 2025/26 com destaque para o município de Irani, com 234 sacas por hectare O Meio-Oeste catarinense caminha para uma safra de milho com produtividade elevada. Levantamento preliminar do Giro da Safra 2025/26 aponta rendimento médio de 204,1 sacas por hectare, com destaque para Irani, que registrou a maior produtividade da região, com 234 sacas por hectare. Até o mom
26 de mar.3 min de leitura


Coocam impulsiona atuação no Paraná ao lado da Brasmax
Participação no Tour do Máximo Rendimento, em Castro (PR), reforça a expansão de mercado da cooperativa e seu compromisso com o produtor A Coocam vem fortalecendo seu alcance no Paraná e compareceu ao Tour do Máximo Rendimento, realizado no dia 19 de março, em Castro (PR). Promovido pela Brasmax, o encontro reuniu multiplicadores e agricultores em uma agenda técnica voltada à avaliação de novas genéticas e tendências do setor. O envolvimento da cooperativa nessa iniciativa co
26 de mar.2 min de leitura


Sistema OCESC debate impactos da MP nº 1.343/2026
A discussão ocorreu em reunião nacional do Conselho Consultivo do Ramo Transporte Na última segunda-feira, 23, o Sistema OCESC participou da reunião nacional do Conselho Consultivo do Ramo Transporte, que tratou dos impactos da Medida Provisória nº 1.343/2026 para as cooperativas do setor. O encontro reuniu lideranças e técnicos para avaliar os efeitos imediatos da norma sobre a contratação de fretes, rotinas operacionais e requisitos de conformidade. “A MP muda o eixo do ris
26 de mar.3 min de leitura


Duas cooperativas catarinenses vencem o Prêmio ANEEL de Satisfação do Consumidor 2025
Além das vencedoras, outras três cooperativas catarinenses chegaram à final Nesta quarta-feira, 25, as cooperativas catarinenses Coopercocal, de Cocal do Sul, e CODESAM, de Benedito Novo, foram reconhecidas como vencedoras do Prêmio ANEEL de Satisfação do Consumidor 2025. A premiação destaca as distribuidoras de energia elétrica mais bem avaliadas pelos consumidores brasileiros, com base nos resultados do Índice ANEEL de Satisfação do Consumidor (Iasc), apurado a partir de pe
26 de mar.3 min de leitura


Sistema pioneiro no Brasil para rastreamento de leite materno e fórmulas infantis
Tecnologia inédita assegura rastreabilidade completa no processo de manipulação e administração de dietas do lactário e Central de Nutrição Enteral (CNE) no Hospital Unimed Chapecó Na rotina da Unidade de Nutrição Enteral e Lactário (Unel) do Hospital Unimed Chapecó, a segurança sempre foi prioridade. Desde a esterilização de utensílios até a manipulação e dispensação dos alimentos infantis, cada detalhe é cuidadosamente controlado. Agora, esse processo ganha um reforço inédi
26 de mar.4 min de leitura


Cersul realizará Assembleia Geral nesta sexta-feira
A CERSUL realizará, nesta sexta-feira (27), mais uma Assembleia Geral, um dos momentos mais importantes do cooperativismo, voltado à transparência, prestação de contas e participação dos associados nas decisões. Reconhecida pelos resultados e pela proximidade com a comunidade, a CERSUL se destaca como a cooperativa com a energia elétrica residencial mais barata praticada de Santa Catarina e a segunda mais barata do Brasil, refletindo o compromisso com eficiência, gestão respo
26 de mar.1 min de leitura


Seguro rural recua em 2025 e acende alerta no agro
O mercado de seguro rural registrou retração em 2025, interrompendo um ciclo de crescimento observado nos anos anteriores e acendendo um alerta sobre os mecanismos de proteção financeira no agro brasileiro. Dados da Confederação Nacional das Seguradoras (CNseg) indicam que a arrecadação do segmento caiu 8,8% no último ano, passando de R$ 14,2 bilhões em 2024 para R$ 12,9 bilhões em 2025. O recuo ocorre em um contexto de redução dos recursos destinados à subvenção ao prêmio e
26 de mar.1 min de leitura


Cooperativa Tradição inaugura indústria em Pato Branco (PR)
A Cooperativa Agroindustrial Tradição do Paraná inaugura, nesta semana em Pato Branco, no Paraná, uma Indústria de Óleo e Farelo de Soja com investimento de R$ 770 milhões, consolidando um dos maiores projetos industriais recentes do agronegócio no Sul do Brasil e redefinindo a capacidade de processamento de soja da região. O novo Complexo terá capacidade para processar até 3 mil toneladas de soja por dia, fortalecendo a industrialização no campo e reduzindo a dependência do
26 de mar.1 min de leitura


Protagonismo feminino é tema de palestra na Fecoagro
Entre histórias e melodias, um convite ao protagonismo ganhou forma e emoção. A Fecoagro promoveu, nos dias 13 e 20 de março de 2026, a palestra “Protagonismo Feminino”, realizada na matriz, em Florianópolis, e na Indústria de Fertilizantes, em São Francisco do Sul, com apoio do Sescoop/SC. A iniciativa reuniu colaboradoras para um momento de reflexão sobre o papel da mulher na construção de suas trajetórias pessoais, profissionais e sociais. Com o objetivo de estimular a aut
26 de mar.1 min de leitura


Nova sede da Unimed SC ganha espaço da Unicred e reforça união cooperativista
Parceria aproxima ainda mais cooperativas médicas e de crédito em Santa Catarina A intercooperação tem espaço especial na sede nova do Grupo Unimed SC, em Joinville. Foi inaugurada na noite de 16 de março a Sala Unicred no prédio institucional e administrativo da Federação Unimed, que iniciou oficialmente suas atividades em outubro de 2025. A sala fica ao lado da plenária onde acontecem os principais debates, as Reuniões de Singulares e as Assembleias Gerais estaduais, transf
25 de mar.2 min de leitura


Coopercocal inicia inscrições para a Escolinha de Futebol Suíço
Iniciaram nesta segunda-feira, 23, as inscrições para a Escolinha de Futebol Suíço, da Cooperativa Elétrica de Cocal do Sul (Coopercocal). O projeto é voltado para crianças e adolescentes de 4 a 15 anos e será realizado na sede esportiva da cooperativa, na Linha Tigre. “O esporte tem um papel fundamental na vida das crianças. Ele ajuda na integração, tira os jovens das ruas e contribui diretamente para o desenvolvimento socioeducacional. Além disso, praticar atividade física
25 de mar.1 min de leitura


26º SBSA Commodities em foco: desafios logísticos e incertezas do mercado
Os desafios logísticos e as incertezas que impactam o comércio internacional de commodities agrícolas estarão em pauta na programação científica do 26º Simpósio Brasil Sul de Avicultura (SBSA). Promovido pelo Núcleo Oeste de Médicos Veterinários e Zootecnistas (Nucleovet), o tema Commodities em foco: superando barreiras logísticas e incertezas do futuro será apresentado pelo especialista, Arene Trevisan, no dia 7 de abril, às 16h, no Centro de Cultura e Eventos Plínio Arlindo
25 de mar.4 min de leitura


Projeto Moradia para jovens e mulheres está em operação e incentiva a permanência no campo
Jovens e mulheres do meio rural catarinense já podem acessar uma nova linha de apoio para investir na construção ou reforma de suas casas. A Secretaria de Estado da Agricultura e Pecuária (Sape) colocou em operação o Projeto Moradia para Jovens e Mulheres, iniciativa que integra o Pronampe Agro SC e amplia o acesso à habitação no campo com condições mais acessíveis de financiamento. O Programa Moradia para Jovens e Mulheres é operacionalizado em parceria com a Epagri. O públi
25 de mar.2 min de leitura


STF abre caminho para acordo sobre moratória da soja
O Supremo Tribunal Federal (STF) sinalizou a possibilidade de construção de um acordo entre produtores rurais e empresas tradings no processo que analisa os efeitos da Moratória da Soja. A Aprosoja avalia a decisão como um avanço relevante no debate, ao reconhecer a necessidade de conciliação em um tema considerado complexo e com impactos diretos sobre o setor produtivo. Segundo a entidade, a evolução do caso demonstra que princípios como livre iniciativa, direito de proprie
25 de mar.1 min de leitura
bottom of page




